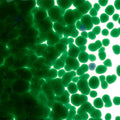
Kelly Green Transparent, Coarse Frit, Fusible

Kelly Green Transparent, Coarse Frit, Fusible
001145-0003-F
Kelly Green delivers a bright, confident green rooted in graphic design and modern color systems.
Energetic without excess, it brings immediacy and clarity to a palette.
Pickup currently not available
Overview
Details
You Might Also Like
Working with Glass
Projects
Need a creative jumpstart? Bullseye has pre-designed projects that can be followed, and then adapted to suit your own aethetics. Want to see what other glass artists are working on? Find an artist survey or exhibition catalog. You can also visit Bullseye Projects, and Bullseye Studio for inspiration.
Classes
Bullseye Glass offers a diverse curriculum that suits any skill level. Choose from online, live classes to in-person workshops and equipment orientations. You can find them at classes.bullseyeglass.com.